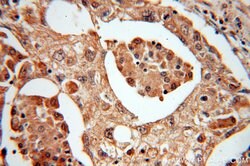

Promotional price valid on web orders only. Your contract pricing may differ. Interested in signing up for a dedicated account number?
Learn More
Learn More
MTH1 Rabbit anti-Human, Mouse, Rat, Polyclonal, Proteintech


Rabbit Polyclonal Antibody
Supplier: Proteintech Group Inc 167051AP150UL

Description
Oxygen radicals damage chromosomal DNA causing cell death and inducing mutations. Among the various classes of DNA damage caused by oxygen radicals, an oxidized form of guanine base (8-oxoguanine) appears to be important as it can pair with cytosine and adenine and G:C to T:A transversion mutation occurs. A significant amount of 8-OxoG is formed in the chromosomal DNA of mammalian cells, with most damaged nucleotides excised from the DNA and excreted in the urine. Along with 8-oxoG being present in oxidatively damaged DNA, 8-oxo-deoxyguanosine (8-oxo-dGTP) is formed in the nucleotide pool during normal cellular metabolism and following oxidative stress. The 8-oxo-dGTP nucleotide can be incorporated in DNA during polymerization and can result in a mispairing unless repaired. MTH converts 8-oxo-dGTP in the nucleotide pool to the monophosphate and prevents the misincorporation of 8-oxo-dGTP into DNA (Figure courtesy of Dr. Mark Kelley). MTH also recognizes 8-oxo-rGTP, which could incorporate into RNA during gene transcription leading to missense or nonsense protein production.Specifications
| MTH1 | |
| Polyclonal | |
| Unconjugated | |
| NUDT1 | |
| MTH 1, MTH1, NUDT1 | |
| Rabbit | |
| Antigen Affinity Chromatography | |
| RUO | |
| 117260, 17766, 4521 | |
| -20°C | |
| Liquid |
| Immunocytochemistry, Immunofluorescence, Immunohistochemistry (Paraffin), Western Blot | |
| 0.13 mg/mL | |
| PBS with 50% glycerol and 0.02% sodium azide; pH 7.3 | |
| P36639, P53368, P53369 | |
| Nudt1 | |
| MTH1 Fusion Protein Ag10103 | |
| 150 μL | |
| Primary | |
| Human, Mouse, Rat | |
| Antibody | |
| IgG |
Product Content Correction
The Fisher Scientific Encompass Program offers items which are not part of our distribution portfolio. These products typically do not have pictures or detailed descriptions. However, we are committed to improving your shopping experience. Please use the form below to provide feedback related to the content on this product.
Product Title
Spot an opportunity for improvement?Share a Content Correction